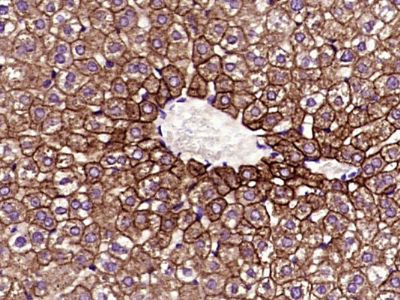
产品细节图片2

万千商家帮你免费找货
0 人在求购买到急需产品
- 详细信息
- 询价记录
- 文献和实验
- 技术资料
- 免疫原:
KLH conjugated
- 亚型:
IgG
- 形态:
冻干粉
- 保存条件:
Store at -20 °C for one year
- 克隆性:
多克隆
- 标记物:
见说明书
- 适应物种:
见说明书
- 宿主:
Rabbit
- 应用范围:
WB=1:500-2000 ELISA=1:500-1000 IHC-P=1:400-800 IHC-F=1:400-800 IF=1:100-500
- 浓度:
1mg/ml
- 靶点:
见说明书
- 抗体英文名:
Cytokeratin 8
- 抗体名:
细胞角蛋白8单克隆免疫组化荧光抗体
- 规格:
100ul
中文名称细胞角蛋白8单克隆抗体
别 名card2; Cardiac autoantigen 2 120kD; CK 8; CK8; CK-8; ck8; Cyk 8; cyk8; CYKER; Cytokeratin endo A; Cytokeratin-8; Cytokeratin8; DreK8; EndoA; k0; CYK8; k2c8; K2C8_HUMAN; k8; Keratin 8; Keratin type ii cytoskeletal 8; Keratin, type II cytoskeletal 8; Keratin-8; Keratin8; KO; Krt 2.8; Krt 8; krt8; KRT-8; MGC118110; MGC174782; MGC53564; MGC85764; sb:cb186; Type-II keratin Kb8.
规格50ul 100ul
研究领域肿瘤 细胞生物 信号转导
抗体来源Mouse
克隆类型Monoclonal
克 隆 号10A8
交叉反应 Human, Mouse, Rat,
产品应用IHC-P=1:400-800 IHC-F=1:400-800 ICC=1:100-500 IF=1:200-800 (石蜡切片需做抗原修复)
not yet tested in other applications.
optimal dilutions/concentrations should be determined by the end user.
分 子 量53kDa
细胞定位细胞核 细胞浆 细胞膜
性 状Lyophilized or Liquid
浓 度1mg/ml
免 疫 原Recombinant human CK8:
亚 型IgG
纯化方法affinity purified by Protein G
储 存 液0.01M TBS(pH7.4) with 1% BSA, 0.03% Proclin300 and 50% Glycerol.
保存条件Store at -20 °C for one year. Avoid repeated freeze/thaw cycles. The lyophilized antibody is stable at room temperature for at least one month and for greater than a year when kept at -20°C. When reconstituted in sterile pH 7.4 0.01M PBS or diluent of antibody the antibody is stable for at least two weeks at 2-4 °C.
PubMedPubMed
产品介绍background:
This gene is a member of the type II keratin family clustered on the long arm of chromosome 12. Type I and type II keratins heteropolymerize to form intermediate-sized filaments in the cytoplasm of epithelial cells. The product of this gene typically dimerizes with keratin 18 to form an intermediate filament in simple single-layered epithelial cells. This protein plays a role in maintaining cellular structural integrity and also functions in signal transduction and cellular differentiation. Mutations in this gene cause cryptogenic cirrhosis. Alternatively spliced transcript variants have been found for this gene. [provided by RefSeq, Jan 2012].
Function:
Together with KRT19, helps to link the contractile apparatus to dystrophin at the costameres of striated muscle.
Subunit:
Heterotetramer of two type I and two type II keratins. KRT8 associates with KRT18. Associates with KRT20. Interacts with HCV core protein and PNN. When associated with KRT19, interacts with DMD. Interacts with TCHP. Interacts with APEX1.
Subcellular Location:
Cytoplasm. Nucleus, nucleoplasm. Nucleus matrix.
Tissue Specificity:
Observed in muscle fibers accumulating in the costameres of myoplasm at the sarcolemma membrane in structures that contain dystrophin and spectrin. Expressed in gingival mucosa and hard palate of the oral cavity.
Post-translational modifications:
Phosphorylation on serine residues is enhanced during EGF stimulation and mitosis. Ser-74 phosphorylation plays an important role in keratin filament reorganization.
O-glycosylated. O-GlcNAcylation at multiple sites increases solubility, and decreases stability by inducing proteasomal degradation.
O-glycosylated (O-GlcNAcylated), in a cell cycle-dependent manner.
DISEASE:
Defects in KRT8 are a cause of cirrhosis (CIRRH) [MIM:215600].
Similarity:
Belongs to the intermediate filament family.
SWISS:
P05787
Gene ID:
3856
Database links:
Entrez Gene: 3856 Human
Entrez Gene: 16691 Mouse
Entrez Gene: 25626 Rat
Omim: 148060 Human
SwissProt: P05787 Human
SwissProt: P11679 Mouse
SwissProt: Q10758 Rat
Unigene: 533782 Human
Unigene: 708445 Human
Unigene: 358618 Mouse
Unigene: 11083 Rat
Important Note:
This product as supplied is intended for research use only, not for use in human, therapeutic or diagnostic applications.
结构蛋白(Structural Proteins)
上皮细胞胞质中的骨架蛋白除微丝(肌动蛋白)、微管蛋白外,主要是细胞角蛋白(cytokeratins,CK)。CK8也是上皮细胞的特征性标记物:CK8存在于某些正常腺上皮及其肿瘤,包括许多导管上皮和腺上皮,如结肠、胃、小肠、气管的上皮和尿路上皮。CK8主要用于腺癌和导管癌的诊断,鳞状细胞癌一般不表达CK8。

Paraformaldehyde-fixed, paraffin embedded (Human colon cancer); Antigen retrieval by boiling in sodium citrate buffer (pH6.0) for 15min; Block endogenous peroxidase by 3% hydrogen peroxide for 20 minutes; Blocking buffer (normal goat serum) at 37°C for 30min; Antibody incubation with (Cytokeratin 8) Monoclonal Antibody, Unconjugated (bsm-33061M) at 1:400 overnight at 4°C, followed by a conjugated secondary (sp-0023) for 20 minutes and DAB staining.
Paraformaldehyde-fixed, paraffin embedded (mouse liver tissue); Antigen retrieval by boiling in sodium citrate buffer (pH6.0) for 15min; Block endogenous peroxidase by 3% hydrogen peroxide for 20 minutes; Blocking buffer (normal goat serum) at 37°C for 30min; Antibody incubation with (Cytokeratin 8) Monoclonal Antibody, Unconjugated (bsm-33061M) at 1:400 overnight at 4°C, followed by operating according to SP Kit(Mouse)(sp-0024) instructionsand DAB staining.

Paraformaldehyde-fixed, paraffin embedded (rat liver tissue); Antigen retrieval by boiling in sodium citrate buffer (pH6.0) for 15min; Block endogenous peroxidase by 3% hydrogen peroxide for 20 minutes; Blocking buffer (normal goat serum) at 37°C for 30min; Antibody incubation with (Cytokeratin 8) Monoclonal Antibody, Unconjugated (bsm-33061M) at 1:400 overnight at 4°C, followed by operating according to SP Kit(Mouse)(sp-0024) instructionsand DAB staining.

Paraformaldehyde-fixed, paraffin embedded (Human cervical cancer); Antigen retrieval by boiling in sodium citrate buffer (pH6.0) for 15min; Block endogenous peroxidase by 3% hydrogen peroxide for 20 minutes; Blocking buffer (normal goat serum) at 37°C for 30min; Antibody incubation with (Cytokeratin 8) Monoclonal Antibody, Unconjugated (bsm-33061M) at 1:500 overnight at 4°C, followed by a conjugated Goat Anti-Mouse IgG antibody (bs-0296G-CY3) for 90 minutes, and DAPI for nuclei staining.

Paraformaldehyde-fixed, paraffin embedded (Human stomach cancer); Antigen retrieval by boiling in sodium citrate buffer (pH6.0) for 15min; Block endogenous peroxidase by 3% hydrogen peroxide for 20 minutes; Blocking buffer (normal goat serum) at 37°C for 30min; Antibody incubation with (Cytokeratin 8) Monoclonal Antibody, Unconjugated (bsm-33061M) at 1:500 overnight at 4°C, followed by a conjugated Goat Anti-Mouse IgG antibody (bs-0296G-FITC) for 90 minutes, and DAPI for nuclei staining.

Paraformaldehyde-fixed, paraffin embedded (Human colon cancer); Antigen retrieval by boiling in sodium citrate buffer (pH6.0) for 15min; Block endogenous peroxidase by 3% hydrogen peroxide for 20 minutes; Blocking buffer (normal goat serum) at 37°C for 30min; Antibody incubation with (Cytokeratin 8) Monoclonal Antibody, Unconjugated (bsm-33061M) at 1:500 overnight at 4°C, followed by a conjugated Goat Anti-Mouse IgG antibody (bs-0296G-CY3) for 90 minutes, and DAPI for nuclei staining.

Paraformaldehyde-fixed, paraffin embedded (Human colon cancer); Antigen retrieval by boiling in sodium citrate buffer (pH6.0) for 15min; Block endogenous peroxidase by 3% hydrogen peroxide for 20 minutes; Blocking buffer (normal goat serum) at 37°C for 30min; Antibody incubation with (Cytokeratin 8) Monoclonal Antibody, Unconjugated (bsm-33061M) at 1:400 overnight at 4°C, followed by a conjugated Goat Anti-Mouse IgG antibody (bs-0296G-FITC) for 90 minutes, and DAPI for nuclei staining.
风险提示:丁香通仅作为第三方平台,为商家信息发布提供平台空间。用户咨询产品时请注意保护个人信息及财产安全,合理判断,谨慎选购商品,商家和用户对交易行为负责。对于医疗器械类产品,请先查证核实企业经营资质和医疗器械产品注册证情况。
- 作者
- 内容
- 询问日期
 文献和实验
文献和实验1.材料 (1) 免疫过的血清抗体滴度高的Balb/c鼠。 (2) 1640培养液 (3) 2.5%FCS-1640营养液 2.操作方法 (1) 拉颈或用CO2 处死小白鼠。 (2) 将小鼠放于70%酒精中浸泡消毒,取出固定于板上,在无菌条件下取脾。 (3) 把脾放入5ml含有2.5%FCS的1640液中,冰浴下轻轻洗去脾上的红血球。 (4) 用镊子轻轻挤压脾,做成脾细胞悬液,用毛细管将悬液
融合的方法很多,常用的有转动法和离心法。 融合时脾细胞和骨髓瘤细胞的比例为1:1至10:1不等。3:1或5:1最为常用。 1. 试剂与材料 (1) 供融合用的脾细胞及骨髓瘤细胞。 (2) 1640培养液100 ml。 (3) 完全1640液100 ml。 (4) 2.5%FCS-1640液50 ml。
融合剂 细胞融合的方法有物理法,如电融合、激光融合,化学融合法和生物融合法,如仙台病毒,此处例举化学融合法中的一种即聚乙二醇融合法。 聚乙二醇( PEG ),在分子量为 200 ~ 700 时,呈无色、无臭的粘稠状液体,分子量大于 1 000 时,呈乳白色蜡状固体,能溶于水、乙醇及其他许多有机溶剂,对热稳定,与许多化学药品不起作用。用作细胞融合剂的聚乙二醇一般选用分子量为 4 000 者,常用浓度为 50 %, pH








